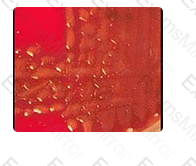
Question # 90

Summer Certification Limited Time 70% Discount Offer - Ends in 0d 00h 00m 00s - Coupon code = getmirror
Pass the ASCP MLT(ASCP) ASCP-MLT Questions and answers with ExamsMirror
Exam ASCP-MLT Premium Access
View all detail and faqs for the ASCP-MLT exam
841 Students Passed
87% Average Score
98% Same Questions
Granulocytes are the most granular population; they have the most side scatter of the cell populations that are listed.
Which of these white blood cell populations would have the MOST side scatter when analyzed using flow cytometry?
The part of the microscope that control the amount of light entering the specimen much like the iris of your eye controls light is called the iris _______________.
Measures Light scatter by particles - Nephelometer
Measures change in vapor pressure - Osmometer
Measures amount of electricity passing between two electrodes - Coulometry
Measures absorbance of light at a specific wavelength - Spectrophotometer
Lab operations
Matching
1. Measures Light scatter by particles
2. Measures change in vapor pressure
3. Measures amount of electricity passing between two electrodes
4. Measures absorbance of light at a specific wavelength
The part of the microscope that holds the objective lenses is called the _______________.
Myoglobin release is strongly associated with muscle damage; therfore, it would most closely match a diagnosis of massive muscle trauma in this question.
Myoglobinuria is MOST likely to be noted in urine specimens from patients with which of the following disorders?
No HLA matching is performed for corneal tissue transplants as the cornea occupies a privileged site not usually seen by the immune system. This term has been coined "immune privileged".
Corneal tissue may be transplanted successfully from one patient to another because:
Waived tests are those considered to have an insignificant risk of erroneous results. Which of the following is NOT an example of a waived test?
The correct answer is Trichophyton rubrum. The tiny microconidia are lined up in a "birds on the fence" arrangement along the hyphal strand transversing the field of view (yellow arrows). Two pencil-shaped, smooth walled macroconidia are also seen in the lower left field of view (red arrows).
Trichophyton verrucosum may produce microconidia in small quantities. However, they are irregularly arranged with little tendency to line up along the hyphae. Antler hyphae and string bean macroconidia are characteristic of this species.
One of the key characteristics in the identification of Epidermophyton floccosum is the inability of this dermatophyte to produce microconidia. Two to four-celled, club-shaped macroconidia are produced, usually in clusters of two or three.

The profusion of tiny microconidia lining up along the hyphae in this photomicrograph is characteristic of which of the following organisms?
Which immune elements are involved in a POSITIVE TB skin test?
Alkaline phosphatase, or ALP, is present in kidneys, liver, intestines, bone, and the placenta. The liver makes the largest amount of ALP. Some of the conditions associated with increased levels of ALP include: damaged liver cells, rapid bone growth (during puberty), bone diseases, or a disease that affects how much calcium is in the blood (hyperparathyroidism), and vitamin D deficiency.
Chemistry
Isoenzymes of alkaline phosphatase occur in:
RAST tests, or Radioallergosorbent tests, are used to screen for an allergy to a specific substance or substances if a person presents with allergy-like symptoms.
The assay which is most helpful in identifying specific allergens is:
PCT usually rises within 3-6 hours of infection. CRP also increases rapidly following infection, but is not as specific for infection as PCT. A rise in CRP could also occur with SIRS. Lactic acid is usually used to detect and monitor impaired circulation and tissue oxygenation in critically ill patients.
Chemistry
Of the three laboratory tests that are listed, which has proven to be most effective for early differentiation of systemic inflammatory response syndrome (SIRS) from sepsis due to its increase following infection and higher specificity?
A positive DAT is consistent with a diagnosis of hemolytic disease of the newborn. A hemoglobin performed on the cord blood serves as an indicator of the severity of the disease.
In order to detect the presence of antibodies fixed on the RBC's of newborns one should:
Overcentrifugation may cause either a false negative result (if too much agitation is required for resuspension), or a false positive, (if centrifuged clumps cannot be completely dispersed). High concentration of IgG paraprotein, and failure to adequately wash cells can leave unbound IgG which will neutralize antiglobulin reagent. Delay of addition of antiglobulin reagent may allow previously bound IgG antibody to dissociate from red cells.
Blood bank
Which of the following might cause a false positive indirect antiglobulin test:
Assuming an alpha hemolytic reaction (not well seen in the image), viridans streptococcus and S. pneumoniae are the two possible responses. However, these colonies are far too mucoid for viridans streptococci; therefore, S. pneumoniae is the most likely choice. Also, the colonies are much too large and the hemolytic reaction is wrong for S. pyogenes or S. agalactiae.
A patient was admitted to the hospital recently with an obvious infection. A sputum specimen was submitted and the microbiologist inoculated it to sheep blood agar. Based on the colony morphology and the alpha hemolysis seen in the image to the right, the most likely identification is:
TOP CODES
Top selling exam codes in the certification world, popular, in demand and updated to help you pass on the first try.
